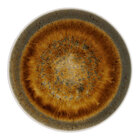

Porcelain Dinnerware
Platters and Trays
Shop Platters and TraysPlates
Shop PlatesCups, Mugs, and Saucers
Shop Cups, Mugs, and SaucersBowls
Shop BowlsFilter Porcelain Dinnerware by
Brand
Edge Style
Color
Shape

Acopa
SUGGESTED VENDOR

Libbey

Reserve by Libbey

Oneida

Arcoroc

10 Strawberry Street

Schonwald

Villeroy & Boch

Bon Chef

RAK Porcelain

International Tableware

CAC China

American Metalcraft

Front of the House

Corona by GET

Sant' Andrea

BauscherHepp

Luzerne

Heart & Soul

Folio

Ariane

Cosy & Trendy

Robert Gordon by Steelite International Dinnerware

Square
Boasts an angular design for a fresh, modern look

Colored Rim
Add a subtle pop of color to your dinnerware display

Embossed
Subtle designs catch guests’ eyes

Narrow Rim
Features maximum serving space with a slight flair

Raised Rim
Easily contains sauces and dressings

Scalloped
Gentle, wavy designs compliment delicate dishes

Wide Rim / Rolled Edge
Classic, simple rims draw focus to the center of the dish

Medium Rim

Coupe
Smooth, gentle lines feature a contemporary feel

Bright White
Crisp white lets all other colors pop

White
Standard color allows you to mix and match with ease

Ivory (American White)
Creamy, yellow-white adds a sleek, subtle look

Black
Black adds a combination of bold and modern elegance

Colorful
Easily match your personalized decor or display

Round
Classic, simple shape showcases your best dishes

Oval
Smooth, curved edges add a sleek look

Rectangle
Angular design is modern with ample serving space

Triangle
Intrigues guests and guarantees a second look

Square
Simple design neatly presents your foods

Oblong
Great for presenting food at buffets or events

Unique
Showcase your own personality with different shapes

Wave
Smooth wave like design adds a futuristic look
Filters: